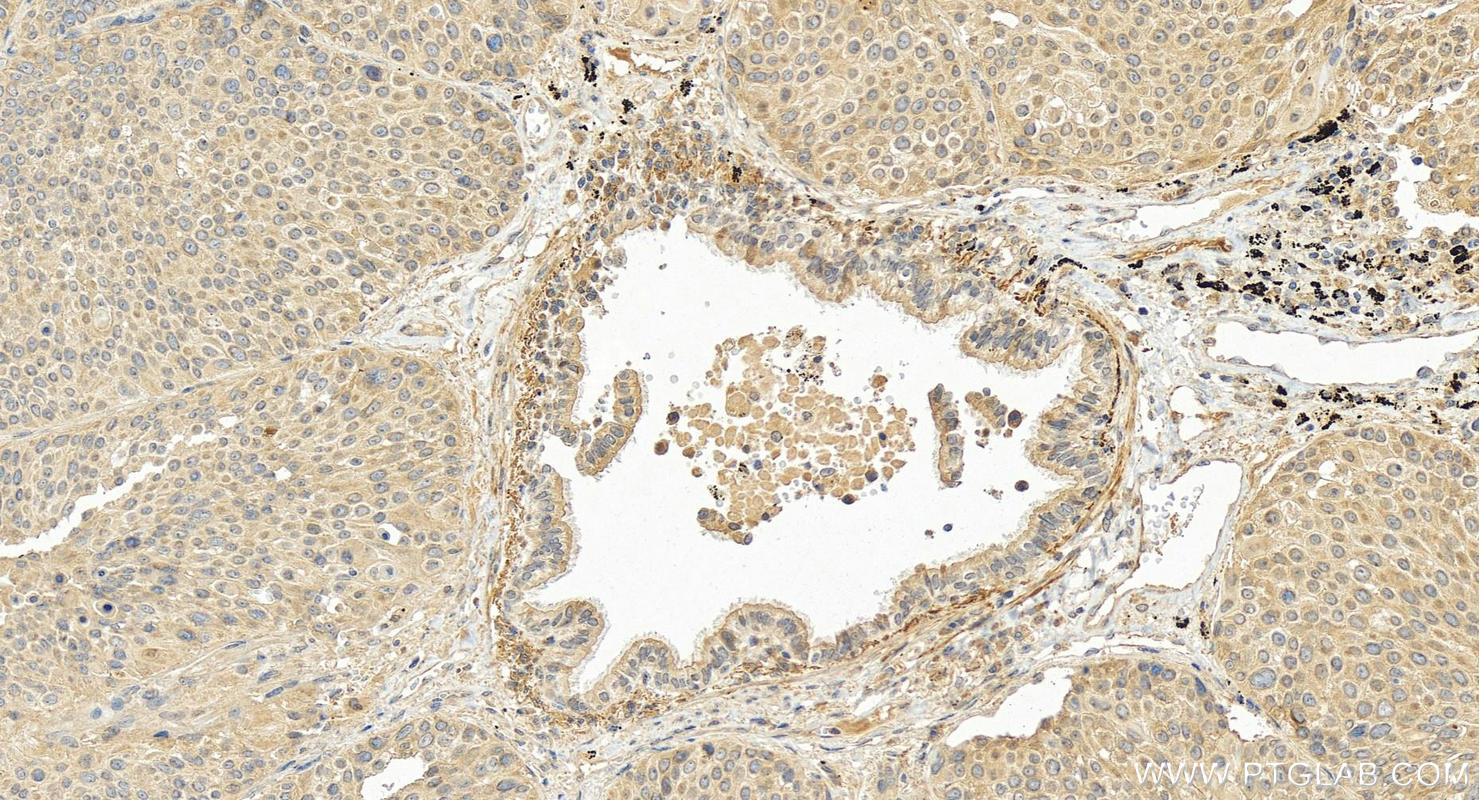
Immunohistochemical analysis of paraffin-embedded human lung squamous cell carcinoma tissue slide using 18108-1-AP (CXCL17 antibody) at dilution of 1:200 (under 20x lens). Heat mediated antigen retrieval with Tris-EDTA buffer (pH 9.0). Immunohistochemistry (IHC) staining of human lung squamous cell carcinoma tissue using CXCL17 Polyclonal antibody (18108-1-AP)

Tested Applications
| Positive IHC detected in | human colon cancer tissue, human breast cancer tissue, human liver cancer tissue, human lung squamous cell carcinoma tissue, human stomach cancer tissue Note: suggested antigen retrieval with TE buffer pH 9.0; (*) Alternatively, antigen retrieval may be performed with citrate buffer pH 6.0 |
| Positive IF-P detected in | human colon cancer tissue |
Recommended dilution
| Application | Dilution |
|---|---|
| Immunohistochemistry (IHC) | IHC : 1:50-1:500 |
| Immunofluorescence (IF)-P | IF-P : 1:50-1:500 |
| It is recommended that this reagent should be titrated in each testing system to obtain optimal results. | |
| Sample-dependent, Check data in validation data gallery. | |
Published Applications
| KD/KO | See 1 publications below |
| WB | See 6 publications below |
| IHC | See 8 publications below |
| IF | See 2 publications below |
Product Information
18108-1-AP targets CXCL17 in WB, IHC, IF-P, ELISA applications and shows reactivity with human samples.
| Tested Reactivity | human |
| Cited Reactivity | human, mouse |
| Host / Isotype | Rabbit / IgG |
| Class | Polyclonal |
| Type | Antibody |
| Immunogen |
CatNo: Ag12516 Product name: Recombinant human CXCL17 protein Source: e coli.-derived, PET28a Tag: 6*His Domain: 23-119 aa of BC093946 Sequence: SLNPGVARGHRDRGQASRRWLQEGGQECECKDWFLRAPRRKFMTVSGLPKKQCPCDHFKGNVKKTRHQRHHRKPNKHSRACQQFLKQCQLRSFALPL Predict reactive species |
| Full Name | chemokine (C-X-C motif) ligand 17 |
| Calculated Molecular Weight | 119 aa, 14 kDa |
| GenBank Accession Number | BC093946 |
| Gene Symbol | CXCL17 |
| Gene ID (NCBI) | 284340 |
| RRID | AB_2878502 |
| Conjugate | Unconjugated |
| Form | Liquid |
| Purification Method | Antigen affinity purification |
| UNIPROT ID | Q6UXB2 |
| Storage Buffer | PBS with 0.02% sodium azide and 50% glycerol, pH 7.3. |
| Storage Conditions | Store at -20°C. Stable for one year after shipment. Aliquoting is unnecessary for -20oC storage. 20ul sizes contain 0.1% BSA. |
Background Information
CXCL17, also known as C-X-C motif chemokine 17, is a relatively newly discovered member of the CXC chemokine family, which plays a multifaceted role in immune responses and other biological processes. CXCL17 has been implicated in several human pathologies, and its role in mediating immune responses is of particular interest. It is involved in the recruitment of immune cells, angiogenesis, and control of microorganisms at mucosal barriers . It is also known to be involved in tumor angiogenesis and has shown both proinflammatory and anti-inflammatory effects. CXCL17 is highly expressed in the gastric mucosa and other mucosal tissues. Its receptor was identified as GPR35 and named CXCR8, although the functional role of this interaction is not yet fully understood. CXCL17's expression is associated with both disease progression and protection in various diseases. It has been linked to pulmonary fibrosis, asthma, lung cancer, and hepatic cancer, where increased expression is associated with disease progression. Conversely, it may play a protective role in pancreatic cancer, autoimmune encephalomyelitis, and viral infections. Research has shown that CXCL17 promotes neutrophil trafficking and plays a role in the early proinflammatory response by facilitating the recruitment of neutrophils to the site of insult . It also exhibits chemoattractant abilities targeting monocytes and macrophages and can induce the production of proangiogenic factors such as vascular endothelial growth factor A from treated monocytes
Protocols
| Product Specific Protocols | |
|---|---|
| IF protocol for CXCL17 antibody 18108-1-AP | Download protocol |
| IHC protocol for CXCL17 antibody 18108-1-AP | Download protocol |
| Standard Protocols | |
|---|---|
| Click here to view our Standard Protocols |
Publications
| Species | Application | Title |
|---|---|---|
Nat Commun Dissecting esophageal squamous-cell carcinoma ecosystem by single-cell transcriptomic analysis. | ||
J Dermatol Sci CXCL17-mediated downregulation of type I collagen via MMP1 and miR-29 in skin fibroblasts possibly contributes to the fibrosis in systemic sclerosis. | ||
Int J Med Sci OCT4 promotes lung cancer progression through upregulation of VEGF-correlated chemokine-1
| ||
Curr Issues Mol Biol Loss of CCL28 and CXCL17 Expression and Increase in CCR1 Expression May Be Related to Malignant Transformation of LGBLEL into Lymphoma | ||
Sci Rep A novel tumor microenvironment-related gene signature for prognostic prediction of intrahepatic cholangiocarcinoma. |